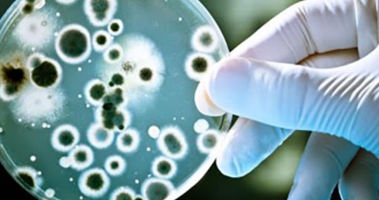

QUE HACEMOS
CARDIOLOGÍA
Consulta médica cardiológica adultos. Estudios de diagnósticos médicos. Electrocardiograma. Eco doppler cardíaco adulto. Ergometría computarizada. Presurometría (mapa).


CIRUGÍA GENERAL Y BARIÁTRICA
Dr. Jorge A Moscardi
El ámbito de la cirugía general es muy amplio. Básicamente incluye el estudio y tratamiento de todas las patologías que ameritan un tratamiento quirúrgico en alguno de sus estados evolutivos. Actualmente la mayoría de las técnicas quirúrgicas se realizan en forma mini-invasiva, es decir, siendo muy poco agresivo con el cuerpo del paciente y, por lo tanto, con mínimo stress y sufrimiento.
Contamos con equipos de última generación para operar a nuestros pacientes (torre Stryker 1588) y estamos entrenados en el uso de modernos métodos de suturas y elementos de corte y coagulación muy seguros. Nuestro equipo humano está compuesto por médicos especialistas en cirugía y altamente capacitados en laparoscopía, de manera que podemos ofrecer las más variadas técnicaslaparoscópicas como en los mejores
centros médicos del país. Entre las cirugías más frecuentemente realizadas encontramos: Colecistectomía (operación de vesícula) Colectomías (operación de colon) Hernioplastías y eventroplastías (operaciones de pared abdominal) Cirugía del cuello y tórax Cirugía de la Obesidad es un subsector de la Cirugía General en donde nos hemos especializado



CLÍNICA MÉDICA
Dra. Florencia Fernández Martínez
Dra. Yanina Laplace
Dra. Karina Fernández
La Medicina Interna es la especialidad médica que se encarga del cuidado integral de la salud del paciente adulto, con un espectro que abarca desde el paciente internado grave hasta la atención ambulatoria. ... El papel principal del especialista en Medicina Interna es convertirse en el médico de cabecera de sus pacientes.


ECOGRAFÍA
Dra. Laura Hurtado
Ecografías de cuello, tórax, abdomen, ginecológicas y obstétricas. Con la más alta tecnología y capacitación a favor de la salud.


ENDOCRINOLOGÍA Y DIABETES
Dra. Emiliana Guanuco

GASTROENTEROLOGÍA
Dr. José Cuelli

INFECTOLOGÍA
Dra. Marina Grand
La infectología es una especialidad médica que se encarga del estudio, la prevención, el diagnóstico y el tratamiento de las enfermedades producidas por agentes infecciosos (bacterias, virus, hongos, parásitos y priones) y está muy relacionada con la medicina interna y de la pediatría .

NEUMONOLOGÍA
Dr. Martín Chertcoff
Un neumonólogo es un médico que se especializa en los pulmones y la respiración. El Dr.Chertcoff atiende pacientes con asma bronquial, EPOC, Neumonía, etc. Realiza estudios diagnósticos como broncoscopia, espirometría, estudios del sueño, etc.


NUTRICIÓN
Lic. Grisel Malvaso
Lic. Marina Gamondi
Lic. Laura Marrone

PSICOLOGÍA
Lic. Ramiro Borzi

PSIQUIATRÍA
Dra. Alejandra Wagner
pacientes, coordinación de terapia grupal en pacientes con obesidad mórbida. Trastornos en la conducta alimentaria. Manifestaciones clínicas. Aspectos neurobiológicos. Asistencia a múltiples congresos y cursos de la especialidad.

TRAUMATOLOGÍA
Dr. Matias Gorostidi
Consultas de ortopedia y traumatología en general, adultos y niños. Cirugía ortopédica y traumatológica, con especialización en miembro superior, hombro, muñeca y mano. Atención de accidentología por todas las ART.


PEDIATRÍA
Dra. Ana Casco
Dra. Virginia Buzeki


OFTALMOLOGÍA
Dra. Miriam Menghini


ALERGOLOGÍA
Dra. Nora Giovino
La alergología es la especialidad médica que se enfoca en el diagnóstico, tratamiento y prevención de las alergias. Las alergias pueden afectar diversas áreas del cuerpo, como las vías respiratorias, la piel y el sistema digestivo, y nuestros especialistas están capacitados para identificar y tratar una alergia. Desde alergias respiratorias como rinitis alérgica, asma y conjuntivitis alérgica, hasta alergias alimentarias, cutáneas y medicamentosas, brindamos un enfoque integral para cada paciente.


GINECOLOGÍA Y OBSTETRICIA
Dr. Juan Bricka
La ginecología y la obstetricia son dos especialidades médicas que se centran en la salud de la mujer, pero abordan diferentes aspectos de su bienestar. La ginecología es la rama de la medicina que se ocupa del diagnóstico y tratamiento de las enfermedades del sistema reproductor femenino. Esto incluye una variedad de condiciones relacionadas con los órganos reproductivos, como los ovarios, las trompas de Falopio, el útero y la vagina. Los ginecólogos realizan exámenes de rutina, como el Papanicolaou, y manejan condiciones como menstruaciones irregulares, endometriosis, infertilidad, infecciones y trastornos hormonales, entre otros. También son responsables de la salud sexual de la mujer, así como de la menopausia y sus síntomas. La obstetricia, por otro lado, se centra en el cuidado de las mujeres durante el embarazo, el parto y el posparto. Los obstetras manejan el seguimiento del embarazo, el diagnóstico de complicaciones y la atención durante el trabajo de parto y el nacimiento. También brindan apoyo
y atención a las mujeres después del parto, incluyendo el cuidado del recién nacido y la salud de la madre. El obstetra debe estar preparado para manejar cualquier eventualidad que pueda surgir durante el embarazo y el parto, así como ofrecer orientación sobre la lactancia y el cuidado infantil. Estas dos especialidades están estrechamente relacionadas y, a menudo, se combinan en la práctica clínica, dado que el bienestar ginecológico puede influir en el embarazo y viceversa. Los médicos que ejercen ambas especialidades se conocen como gineco-obstetras. En resumen, mientras que la ginecología se enfoca en la salud y enfermedades del aparato reproductor femenino en general, la obstetricia se especializa en el periodo del embarazo y el parto. Ambas disciplinas son esenciales para asegurar la salud integral de la mujer a lo largo de su vida.

HEMATOLOGÍA
Dra. Silvina Rosende
La hematología es la especialidad médica que se enfoca en el diagnóstico, tratamiento y prevención de enfermedades relacionadas con la sangre y los órganos encargados de producirla. En nuestra clínica, contamos con un equipo de expertos en hematología para tratar una amplia variedad de trastornos sanguíneos, como
anemia, leucemia, linfomas, hemofilia, etc. Realizamos estudios detallados y pruebas de laboratorio para identificar alteraciones en los glóbulos rojos, blancos y plaquetas. Nuestros especialistas ofrecen planes de tratamiento personalizados que van desde el manejo de enfermedades crónicas hasta terapias avanzadas.

NEFROLOGÍA
Dra. Gabriela Rosende
Cuidar de tus riñones es esencial para mantener tu bienestar general. La nefrología es la especialidad médica que se encarga de diagnosticar, tratar y prevenir enfermedades renales. Nuestro equipo de especialistas trabaja para ofrecerle una atención personalizada y soluciones efectivas. Desde enfermedades como la insuficiencia renal, la hipertensión o la diabetes, hasta trastornos más complejos, proporcionamos un enfoque integral para preservar la salud de tus riñones. Realizamos estudios avanzados y exámenes detallados para detectar problemas a tiempo.

